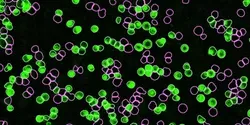
Live-Cell Analysis of Cell Subsets and Heterogeneity

Sartorius
Sartorius is a renowned supplier of laboratory equipment and services, dedicated to providing high-quality solutions for researchers, laboratories, and biopharmaceutical manufacturers. With a commitment to excellence, Sartorius supports scientific endeavors by delivering reliable instruments and consumables, contributing to advancements in research and bioprocessing.All by Sartorius
Filter by
AllArticlesAudioEbooksEventsInfographicsNewsProductsSurveysDocumentsVideosVirtual EventsWebinars